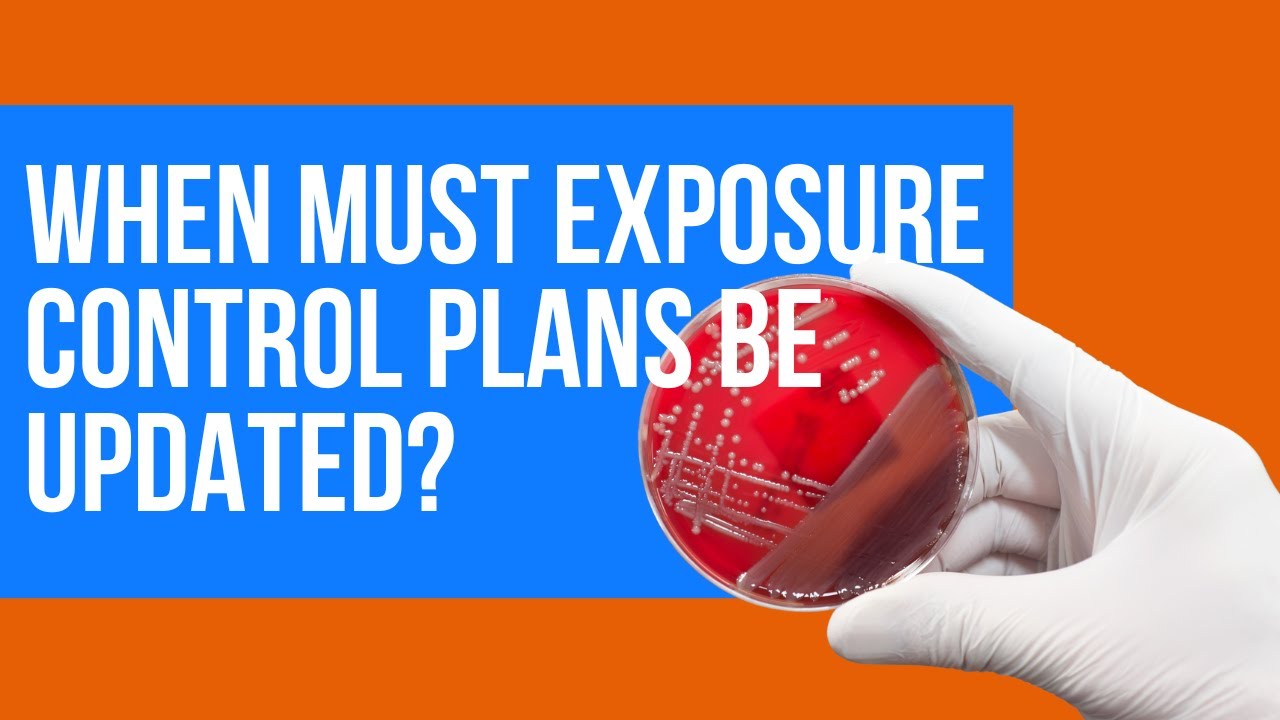
EHS Training: Key Times to Update Your Exposure Control Plans 🛡️

EHS Training: Key Times to Update Your Exposure Control Plans π‘οΈ
Stay compliant and protect your team! Discover when it's essential to review and update your exposure control plans in our latest #EHSTraining with Frontline.

Frontline Data Solutions
314 views β’ Sep 21, 2022
About this video
Welcome to #EHSTraining with Frontline!
Let's talk about exposure control plans! When was the last time you updated or changed your exposure control plan?
00:11 Exposure hazards
00:46 When to update exposure control plans
01:00 Exposure control compliance
About Frontline
Frontline helps companies digitize, simplify and optimize critical safety operations. To learn more about Frontline's EHS software, visit https://www.fldata.com/.
#FrontlineDataSolutions #WorkplaceSafety
Let's talk about exposure control plans! When was the last time you updated or changed your exposure control plan?
00:11 Exposure hazards
00:46 When to update exposure control plans
01:00 Exposure control compliance
About Frontline
Frontline helps companies digitize, simplify and optimize critical safety operations. To learn more about Frontline's EHS software, visit https://www.fldata.com/.
#FrontlineDataSolutions #WorkplaceSafety
Tags and Topics
Browse our collection to discover more content in these categories.
Video Information
Views
314
Likes
1
Duration
1:21
Published
Sep 21, 2022
Related Trending Topics
LIVE TRENDSRelated trending topics. Click any trend to explore more videos.
No specific trending topics match this video yet.
Explore All Trends